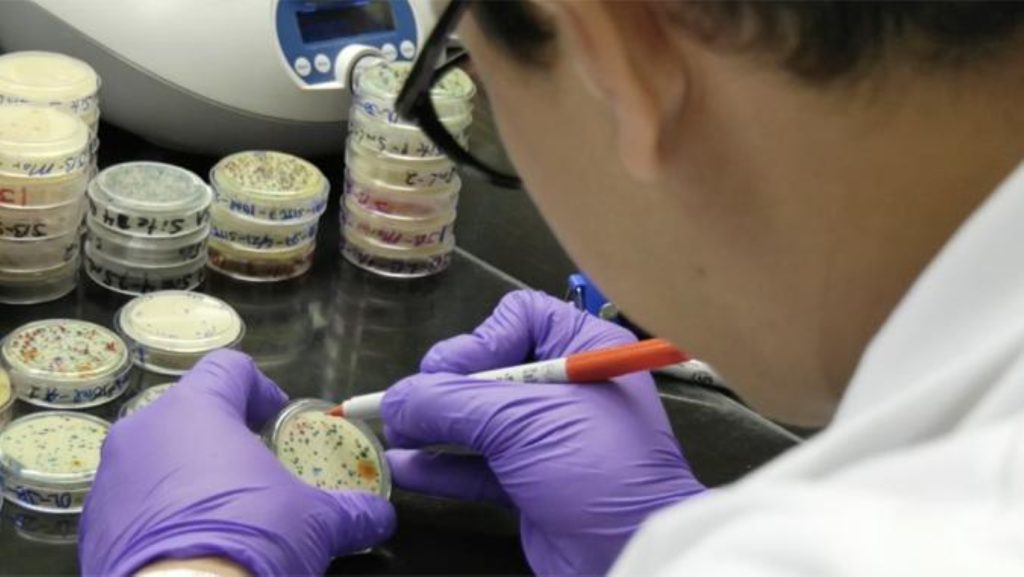

University of Hawaiʻi launched a new office to serve as a central hub for grant support, research development and funding opportunities to help boost scientific discovery, increase research capacity and stimulate workforce development throughout the state.
Hawaiʻi Established Program to Stimulate Competitive Research/Institutional Development Award Office was created to help faculty and students from higher education institutions located in the office’s jurisdiction, which encompasses all of Hawaiʻi, to expand research efforts while enhancing the impact and visibility of Hawaiʻi-based research throughout the nation.
The new office is backed by the Established Program to Stimulate Competitive Research from the National Science Foundation and Institutional Development Award from National Institutes of Health.
“The launch of this office is an important step in strengthening our state’s research capacity and expanding support for faculty and students,” said University of Hawaiʻi President Wendy Hensel in an announcement about the new office. “By building stronger partnerships and increasing access to federal funding, we can accelerate discovery, grow Hawaiʻi’s research workforce and deliver meaningful impact for our communities.”
The Established Program to Stimulate Competitive Research program is a federal initiative designed to strengthen research capacity and competitiveness throughout states, territories and jurisdictions that historically received a smaller share of federal research funding.
National Science Foundation in 2016 awarded University of Hawaiʻi a 5-year $20 million grant for its ʻIke Wai, or Knowledge of Fresh Water, project for geophysical research to better understand the dynamics of freshwater aquifers throughout the islands.
In addition to providing updated information about water flows and capacities, the study helped more accurately map the contaminant flow from subsequent leaks into the aquifer that contributed to the eventual shutdown in 2022 of U.S. Navy’s Red Hill Bulk Fuel Storage Facility on Oʻahu.
University of Hawaiʻi Change Hawaiʻi leverages artificial intelligence, machine learning and high-resolution data to advance climate resilience and ecosystem monitoring throughout the state.
Similarly, the Institutional Development Award program works to broaden geographic distribution of biomedical research funding in states and territories that historically received lower levels of National Institutes of Health research funding.
The program in Hawaiʻi enriches University of Hawaiʻi programs such as:
- University of Hawaiʻi at Mānoa’s Centers of Biomedical Research Excellence and its Diabetic Research Center.
- Hawaiʻi Institutional Development Award Networks of Biomedical Research Excellence, which helps fortify research programs statewide to increase the number of undergraduate students seeking a biomedical science career.
- Center for Pacific Innovations, Knowledge and Opportunities that aids medically underserved populations in Hawaiʻi by improving clinical and translational research infrastructure.
“The launch of the Hawaiʻi [Established Program to Stimulate Competitive Research/Institutional Development Award] Office represents an important step forward in strengthening our state’s innovation ecosystem,” said City and County of Honolulu Office of Economic Revitalization Executive Director Amy Asselbaye in the new office announcement. “By advancing collaboration and increasing local research, we can support scientific discovery while creating pathways for economic diversification, workforce development, long-term resilience for Hawaiʻi and a better quality of life for our people.”
Asselbaye is also a member of the Hawaiʻi Established Program to Stimulate Competitive Research Jurisdictional Steering Committee.
University of Hawaiʻi Office of the Vice President for Research and Innovation oversees and provides administrative support for Hawaiʻi Established Program to Stimulate Competitive Research/Institutional Development Award initiatives.
New office officials are working with Jurisdictional Steering Committee — a strategic advisory body comprised of members from local government, business, higher education, health and community based organizations — for a new Hawaiʻi Science and Technology Plan.
The plan will serve as a 5-year strategic road map to enhance the state’s research competitiveness, economic resilience and workforce through science, technology and data-driven innovation by building on Hawaiʻi’s unique geographical, cultural and ecological strengths.
“The role of the Hawaiʻi [Established Program to Stimulate Competitive Research/Institutional Development Award] Office is to serve as quarterback for a team of outstanding faculty and students from higher education institutions in Hawaiʻi to help secure critical funding and infrastructure for their critical research that impacts not only our state but the world,” said University of Hawaiʻi Interim Vice President for Research and Innovation Chad Walton in the new office announcement. “Armed with a new [science and technology] plan that reflects the state’s research priorities, it is our goal to foster more public-private-academic collaboration to further strengthen our state’s research capacity and, ultimately, our economy.”
